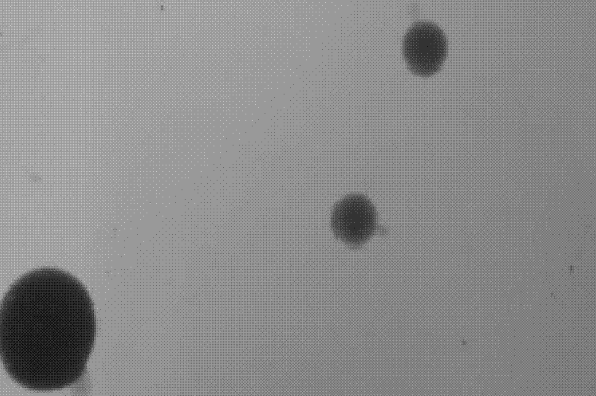
纳米金

DBCO-PEG6-AuNPs ,PEG6-AuNPs-DBCO,二苯并环辛炔-六聚乙二醇-纳米金 的描述
发布时间:2022-07-21     作者:zyl   分享到:
描述:
纳米金即指金的微小颗粒,其直径在1~100nm,具有高 电子密度 、介电特性和 催化作用 ,能与多种生物大分子结合,且不影响其 生物活性 。 由 氯金酸 通过还原法可以方便地制备各种不同粒径的纳米金,其颜色依直径大小而呈红色至紫色。 中文名 纳米金 外文名 AuNPs
产品名称:DBCO-PEG6-纳米金
其他名称:DBCO-PEG6-AuNPs
分子量:1k,2k,3.4k,5k,10k,20k(可按需定制)
质量控制:95%+
存储条件:-20°C,避光,避湿
外 观:粘稠液体或者固体粉末,取决于分子量
注意事项 取用一定要干燥,避免频繁的溶解和冻干
溶解性:溶于大部分有机溶剂,如:DCM、DMF、DMSO、THF等等。在水中有很好的溶解性
西安齐岳生物实验室可以生产销售各类DBCO偶连小分子 高分子以及一些定制类的DBCO产品,齐岳生物可以制备一些DBCO修饰的多肽,核酸,多糖 单糖 寡糖以及蛋白等不同产品。
相关产品:
DBCO-N-ethyl-2-oxopropanamide DBCO-N-乙基-2-氧代丙酰胺
DBCO-PEG-PFP DBCO-PEG--五氟苯酚
DBCO-Benzaldehyde DBCO-苯甲醛
DBCO-PEG-Benzaldehyde DBCO-PEG-聚乙二醇-苯甲醛
DBCO-PEG-Mesylate DBCO-PEG-甲磺酸酯
DBCO-PEG-TPP DBCO-PEG-磷酸三苯酯
状态:固体/粉末/溶液
产地:西安
储存时间:1年
保存:冷藏
用途:科研
厂家:西安齐岳生物科技有限公司




齐岳微信公众号
官方微信
库存查询